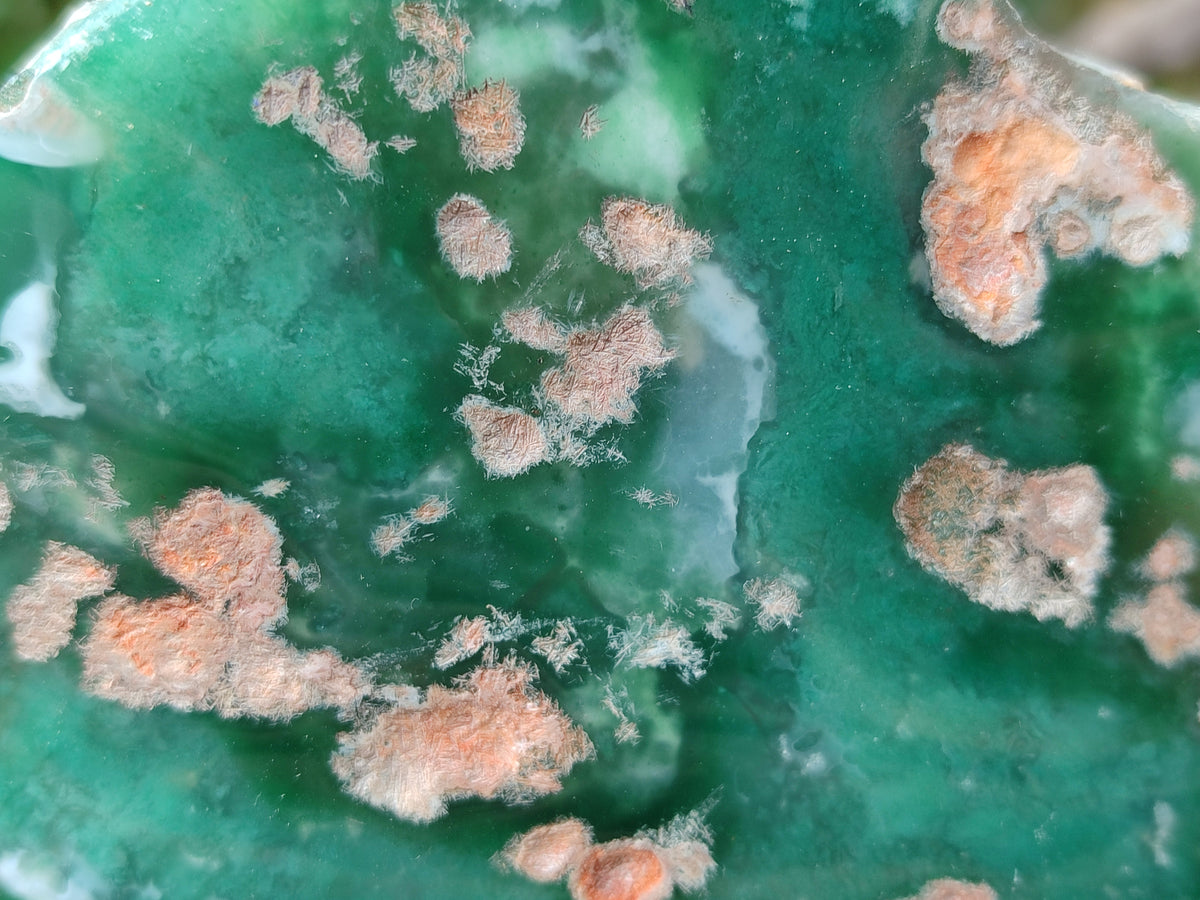
Polished On One Side Emerald Mtorolite Plates x 3 From Mutorashanga, Zimbabwe - Toprock Gemstones and Minerals

PRODUCT DESCRIPTION
Mtorolite: The Exquisite Chrome Chalcedony from Zimbabwe
Emerald Mtorolite is a rare, vibrant green variety of Chrome Chalcedony found only in Zimbabwe. Its color ranges from deep forest green to a lighter emerald hue, caused by trace amounts of Chromium within its structure. This unique mineral is typically opaque with a glassy to waxy luster and is prized for its rich color, often mistaken for Jade due to its resemblance.
PRODUCT MINERALS
Chrome Chalcedony
PRODUCT FEATURES
Trigonal, Etched, Vugs-Cavities
PRODUCT COLOUR
Green
MOHS HARDNESS SCALE
6.5 to 7
PRODUCT DATA
Locality = Mutorashanga, Zimbabwe
Grade = Good to Very Good Grade
Size = 141 - 181 mm
SKU = 161-648-250512GB
PLEASE NOTE: The product title specifies the exact number of individual pieces included in your purchase (eg. x12, x1, x35 etc). “We have 1 in stock” means we have 1(one) complete batch (as per quantity stated in the product title) or 1 (one) unique product available as appropriate. Prices are grade dependent and all items are sold as shown in the product images.
All prices exclude SA VAT. International export clients will not be charged VAT by us, but you may be charged import VAT by customs in your country.
- Gallery